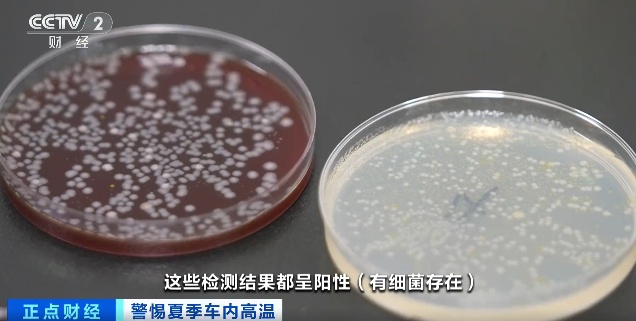
高温暴晒！车里的隔夜水可别喝了！

很多人习惯在车内
放几瓶矿泉水和冰镇饮料
渴了来上几口,解渴又清凉
不过有时我们喝不完
随手放在车内
经过高温暴晒
这些瓶装水和饮料饮用后
会有安全风险吗?
将未开封和开封饮用过的矿泉水和红豆薏米水饮料分组标记,放置在车内前挡风玻璃下,经过72小时高温放置后,送往实验室进行真菌和细菌检测实验。将四组样品标记后,同时放置在特定的环境下,进行真菌细菌的检测实验。
经过实验,未开封的纯净水和红豆薏米水没有检测出来细菌和真菌,而开封的纯净水和红豆薏米水检测结果都呈阳性。
专家提醒,开封过的饮品,长时间放置在高温的车内,再次饮用会有健康风险。

专家表示:开封之后,因为口腔中的细菌可能会进入到这种饮料中,如果经过高温暴晒之后,这种风险会明显增加,随着时间的延长,细菌会越来越多。像红豆薏米水,因为含有大量蛋白质,可能会给细菌提供更多的繁殖条件,变质的时间会更短,所以不建议隔夜饮用。
湖北交警建议大家
新开封的瓶装水最好一次喝完
避免浪费

综合:央视财经、湖北交警


点击右上角![]() 微信好友
微信好友
 朋友圈
朋友圈

点击浏览器下方“ ”分享微信好友Safari浏览器请点击“
”分享微信好友Safari浏览器请点击“ ”按钮
”按钮

点击右上角 QQ
QQ

点击浏览器下方“ ”分享QQ好友Safari浏览器请点击“
”分享QQ好友Safari浏览器请点击“ ”按钮
”按钮
